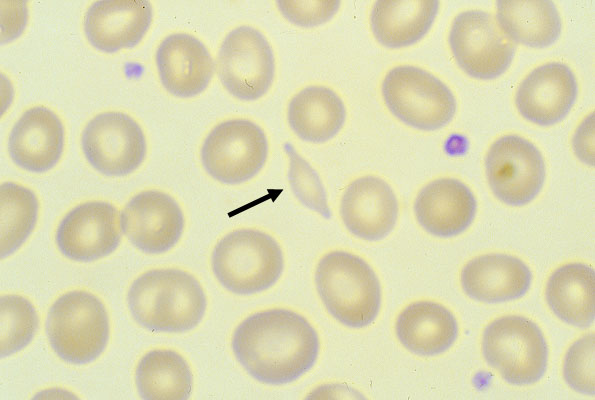

Schistocyte, peripheral blood smear
Click picture to enlarge. Close window to return
Schistocytes (arrow) are fragments of red cells. They are formed when RBCs are damaged, such as in severe burns, microangiopathic anemia (TTP, DIC) and macroangiopathic anemia (prosthetic or pathologic heart valve).